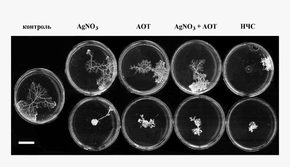

Наночастицы металлов в растворах - биохимический синтез, свойства и применение (1090303), страница 8
Текст из файла (страница 8)
К настоящему времени получены результаты исследований на нескольких биологических объектах – плазмодии низшего гриба Physarum polycephalum, одноклеточных водорослях Chlorella vulgaris, семенах растений, организме млекопитающих и культурированных клетках человека. Действие водных растворов наночастиц сравнивалось с действием растворов АОТ в тех же концентрациях, в которых этот ПАВ присутствует в растворе наночастиц, а также с действием ионов Ag+ , вводившихся в виде водных растворов нитрата серебра. Таким образом, оказывалось возможным (1) выделить биологический эффект наночастиц серебра в совокупном действии наночастиц и АОТ и (2) выяснить, является ли эффект наночастиц следствием действия ионов серебра, что важно для выяснения механизма действия наночастиц. Ниже приведено несколько примеров полученных результатов.
Плазмодий слизевого гриба Physarum Polycephalum
Исследования проводились совместно с Институтом теоретической и экспериментальной биофизики РАН. Плазмодий Physarum polycephalum является удобным тест-объектом для изучения явлений хемотаксиса – двигательной реакции клеток на неблагоприятные химические воздействия из окружающей среды. Он представляет собой многоядерную протоплазму, окруженную общей мембраной и обладающую способностью к неограниченному росту и амебоидному движению. В экспериментах определялось действие наночастиц на двигательную активность и рост плазмодия. Сравнивалось угнетающее действие (характеризующее степень токсичности) водных растворов наночастиц Ag, АОТ и ионов Ag+; эксперименты проводились в водных растворах (уровень двигательной активности тяжа плазмодия), а также на чашках Петри и на пластинках с питательной средой (рост плазмодия).
В
нескольких сериях экспериментов с наночастицами диаметром 8-10 (± 4-6) нм на чашках Петри было показано, что, во-первых, наночастицы Ag в концентрациях ≥ 10-4 M (10.8 мкг/мл) вызывают быструю гибель плазмодия и, во-вторых, при концентрациях, не вызывающих гибели плазмодия (≤ 10-5 M или 1.08 мкг/мл) наночастицы более токсичны, чем AOT, ионы Ag+ или смесь AOT + Ag+ в концентрациях, равных тем, которые вводятся с водным раствором наночастиц. Пример показан на рис.30.
Рис. 30. Распространение плазмодия на агаровой подложке в контроле и в присутствии НЧС, AgNO3 и АОТ. Верхний ряд: AgNO3 – 10-5 М, АОТ – 2.5 * 10-3 %, НЧС – 10-5 М. Нижний ряд: AgNO3 – 10-4 М, АОТ – 2.5 * 10-2 %, НЧС – 10-4 М. Время – 6 час после помещения на подложку стандартных образцов плазмодия. Масштабный отрезок – 1 см.
Видно, что при концентрации наночастиц C(НЧС) = 10-4 M во всех случаях рост плазмодия не происходит, а при C(НЧС) = 10-5 M наблюдается заметное различие в росте плазмодия на среде, содержащей наночастицы, и на трех средах, содержащих нитрат серебра, АОТ и их смесь в соответствующих концентрациях. Ясно также, что «чистый» контроль без всяких добавок неотличим от варианта с AgNO3, и лишь незначительно отличается от двух других случаев, содержащих АОТ. Этот результат подтверждает вывод, сделанный нами ранее в исследованиях на бактериях кишечной палочки, о большей эффективности наночастиц по сравнению с ионами Ag+ в тех же концентрациях. Такой же вывод был сделан другими авторами в исследованиях на бактериях, животных клетках и эмбрионах рыб.
Данные, полученные в исследованиях уровня двигательной активности плазмодия в водном растворе и роста на питательной среде позволили построить следующий ряд сравнительной эффективности: AgNO3 << AOT< AgNO3 +AOT << наночастицы Ag. Таким образом, исследование хемотаксиса на плазмодии показало, что в случае наночастиц токсическое действие серебра многократно усилено, причем эффект усиления не сводится к дестабилизирующему действию на клеточную мембрану поверхностно-активного вещества (АОТ), образующего оболочку мицеллы. Кроме того, более высокая эффективность наночастиц по сравнению с ионами серебра позволяет предположить, что биологическое действие наночастиц не сводится к действию ионов серебра, но может включать иной механизм, в котором важную роль играют сами наночастицы металла.
Проводились также эксперименты с водными растворами наночастиц разного размера с узким распределением: 5.5±2.0 нм и 9.2±2.7 нм. Было обнаружено, что, при одинаковой общей концентрации наночастиц серебра в питательной среде, отрицательная реакция плазмодия более сильно выражена для наночастиц меньшего размера. Результат иллюстрируется рис.31. Зародыш плазмодия помещали на границе между двумя
полосками агара (разделенными промежутком 1 мм), содержащими наночастицы разного размера.
Рис.31. Реакция плазмодия на присутствие наночастиц серебра разного размера
Видно, что рост плазмодия происходит почти исключительно в сторону среды с наночастицами большего размера (SNP5), то есть наблюдается явное «избегание» наночастиц меньшего размера (SNP4). Это подтверждает имеющиеся в литературе данные о большей токсичности наночастиц серебра малого размера. Возможно, влияние размера связано с различием в числе наночастиц на единицу объема среды. В нашем случае это число различается примерно на порядок: SNP4 - 1.48 x 1014; SNP5- 3.16 x 1013 (частиц/мл).
В целом полученные здесь результаты позволяют заключить, что хемотаксис является чрезвычайно чувствительным тестом в исследованиях токсичности наночастиц. Данные, полученные на плазмодии Physarum polycephalum, позволяют рекомендовать подобные тесты для выявления следовых количеств вредных веществ на любых про- или эукариотических клетках, способных к хемотаксису.
Одноклеточная водоросль Chlorella vulgaris
Токсичность наночастиц Ag исследовалась на живых клетках культуры микроводоросли методом микроэлектрофореза на приборном комплексе «Цито-эксперт», в сотрудничестве с Инженерно-техническим центром (лабораторией биотестирования, г.Ижевск). Токсичность наночастиц оценивалась по изменению амплитуды колебаний клеток в переменном электрическом поле, обусловленному уменьшением их поверхностного заряда, который является показателем жизнеспособности клеток. Клетки водоросли в дистиллированной воде инкубировали с наночастицами при различных концентрациях в интервале 10-8 – 10-4 M (0.00108 – 10.8 мкгAg/мл) заданное время, затем определяли индекс токсичности T = (Ac – Acell)/Ac , где Ac and Acell – средние амплитуды колебаний, найденные для контрольной (клетки без наночастиц) и экспериментальной суспензии, соответственно. Независимо определялась токсичность ионов Ag+ и смеси Ag+ +АОТ в соответствующих концентрациях, аналогично тому, как описано выше в экспериментах с плазмодием. Результат показан на рис. 32.
Рис.32. Токсичность наночастиц (AgNP), AgNO3 и смеси AOT + AgNO3 для клеток водоросли Chlorella vulgaris.
Токсичность наночастиц вначале возрастает с увеличением их концентрации, затем остается постоянной в интервале 0.108 мкг/мл (10-6 M) - 10.8 мкг/мл; достигнутый уровень токсичности равен примерно ½ максимального (Т=1). Почти при всех исследованных концентрациях (кроме 10-4 M) наночастицы Ag более токсичны, чем ионы Ag+ или Ag+ + AOT при тех же концентрациях, что и введенные с наночастицами, в согласии с данными, полученными на плазмодии. Таким образом, и в этом случае действие наночастиц не сводится к действию ионов серебра. Одинаковая токсичность всех трех агентов при наибольшей концентрации (10-4 М) объясняется, скорее всего, тем, что клетки уже нежизнеспособны, подобно тому, что наблюдалось при этой концентрации на плазмодии.
Семена растений
Исследовалось действие наночастиц Ag на всхожесть семян арабидопсиса (Arabidopsis thaliana) и сои (Glycine max); данные получены в Институте общей генетики им. Н.И.Вавилова РАН. Оба растения являются известными тест-объектами для изучения влияния различных факторов на генетические характеристики растительных организмов. Сравнивалось влияние водного раствора наночастиц размером 9±6 нм и растворов АОТ в соответствующих концентрациях. Концентрация наночастиц и АОТ в исходном растворе составляла 5*10-3 М и 15*10-3 М, соответственно. Семена предварительно замачивали в дистиллированной воде в течение 24-х часов, затем заливали растворами наночастиц или АОТ и инкубировали еще 24 часа, затем отмывали дистиллятом и ставили на проращивание в стандартных условиях. Оказалось, что присутствие АОТ практически не влияло на всхожесть семян, то есть цитолитический эффект отсутствовал. В случае наночастиц снижение всхожести наблюдалось при концентрациях выше 1*10-3 М (108 мкг/мл), а при более низких концентрациях эффект отсутствовал. Результат эксперимента с семенами арабидопсиса показан на рис.32.
Рис. 32. Всхожесть семян Arabidopsis thaliana при действии наночастиц серебра (НЧС) и АОТ.
Из полученных данных вытекает, что при наиболее высоких концентрациях в исследованном диапазоне водная дисперсия наночастиц серебра более токсична, чем раствор АОТ, что согласуется с рядом токсичности, найденным для плазмодия. Другое следствие состоит в том, что для исследованных семян в широком диапазоне концентраций (5*10-7 - 1*10-3 М) водный раствор наночастиц серебра не токсичен, что указывает на возможность его использования для обработки семян с целью защиты их от поражения патогенными бактериями. В отличие от результатов, полученных на бактериях E.coli, плазмодии и клетках хлореллы, для семян обнаружено сильное цитотоксическое действие ионов Ag+, причины которого пока не выяснены.
Организм млекопитающих
И
сследовалось действие водных растворов наночастиц Ag на длительность жизни мышей линии BALB в возрасте 3-4 мес. (данные Института общей генетики им. Н.И.Вавилова РАН). В задачу исследования входило:1) определение процента выживаемости мышей в зависимости от концентрации введенного раствора наночастиц серебра (НЧС) и 2) установление дозы раствора, вызывающей 50% гибели животных в течение 30 дней после введения (ЛД50/30). Работа проводилась с тем же раствором наночастиц, что и в опытах на семенах растений. Раствор наночастиц (0.2 мл) вводился однократно внутрибрюшинно в различных разведениях; минимальная концентрация наночастиц составляла 0,05*10-3 М. Действие наночастиц сравнивалось с действием растворов АОТ и нитрата серебра в эквивалентных концентрациях. Определение выживаемости проводилось по стандартной методике в течение 30-ти дней после введения растворов. Результаты показаны на рис.33.
Рис. 33. Смертность мышей при инъекции препарата НЧС и раствора АОТ в зависимости концентрации.
Из анализа полученных данных вытекает, что процент гибели был выше в группе с введением наночастиц серебра, чем при введении АОТ. На основании регрессионного анализа данных по выживаемости была определена доза раствора, вызывающая 50% гибели животных. Величина ЛД50/30 составила для наночастиц Ag (2, 75 ±0,66)10-3 М, а для АОТ – (32,6±17,1) *10-3 М. Полученные результаты указывают на достаточно сильный и зависимый от концентрации наночастиц летальный эффект при инъекции у мышей, независимо от пола животных. Существенное различие в величинах ЛД50/30 для наночастиц и АОТ свидетельствует также о меньшей токсичности ПАВ по сравнению с раствором наночастиц, в согласии с выводами, сделанными в ходе исследований плазмодия и семян растений. Введение раствора нитрата серебра не вызывало гибели мышей при всех исследованных концентрациях, что указывает на существенно меньшую токсичность ионов, чем наночастиц серебра, а также на то, что токсическое действие наночастиц не сводится к действию ионов серебра.
Культуры клеток человека
Исследовали действие водных растворов наночастиц Ag на культуры клеток опухолей человека (линии HeLa и U937). Работа проводилась в НИИОПП РАМН с целью получения сведений о механизме действия наночастиц металлов на клетки человека, а также для выяснения возможности использования наночастиц серебра в качестве лекарственного средства в терапии онкологических заболеваний. Клетки снимали с матрасов в логарифмической фазе роста стандартным образом и переносили в 96 луночные планшеты. Через сутки к клеткам добавляли водный раствор наночастиц в разных концентрациях или контрольные растворы (Ag+ , АОТ или смеси Ag+ + АОТ), инкубировали в стандартных условиях роста культур заданное время, после чего клетки отмывали и определяли цитотоксичность исследуемых агентов двумя способами – по уровню функциональной активности митохондрий (МТТ-тест) и внутриклеточных ферментов (ФДА/ПИ –тест). Определялась также возможность переноса наночастиц через клеточную мембрану путем эндоцитоза посредством блокирования активного транспорта (инкубация клеток при 4оС). Было обнаружено, что для обоих типов клеток токсичность наночастиц выше, чем соответствующих концентраций АОТ, ионов Ag+ и смеси Ag+ + АОТ, что может говорить о наличии специфической составляющей в действии наночастиц, в согласии с выводами, сделанными на других исследованных объектах.